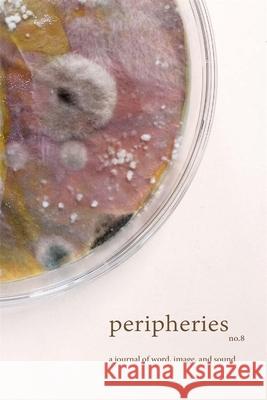
Peripheries: A Journal of Word, Image, and Sound, No. 8 Sherah Bloor 9780674305090 Harvard University Press - książka

Peripheries: A Journal of Word, Image, and Sound, No. 8 » książka
topmenu
Peripheries: A Journal of Word, Image, and Sound, No. 8
ISBN-13: 9780674305090 / Angielski
Peripheries: A Journal of Word, Image, and Sound, No. 8
ISBN-13: 9780674305090 / Angielski
cena promocyjna 78,22
(netto: 74,50 VAT: 5%)
82,34
Rabat: -5%
Najniższa cena z 30 dni: 82,01
(netto: 74,50 VAT: 5%)
Rabat: -5%
Najniższa cena z 30 dni: 82,01
Książka dostępna od:
12-05-2026
12-05-2026
Darmowa dostawa!